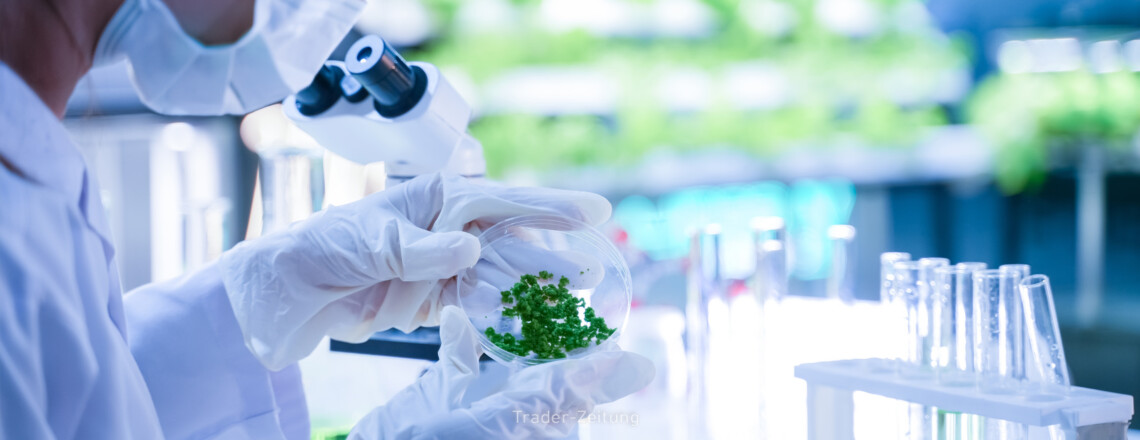

La acción de Neurocrine ha terminado la consolidación y se acerca al máximo histórico!
La acción de Neurocrine ha terminado la consolidación y se acerca al máximo histórico!
Tiempo de lectura: 1 minuto
Neurocrine Biosciences sigue siendo una de las acciones de biotecnología más emocionantes. Este año, la empresa ha tenido un inicio mucho más fuerte de lo esperado con el medicamento Crenessity, logrando casi 100 millones en ingresos solo en el tercer trimestre, como los analistas habían pronosticado para el año completo. Debido a su alta efectividad, es probable que se alcance rápidamente un volumen de ventas anual de 1 mil millones de dólares. Además, el principal motor de crecimiento INGREZZA ofrece un potencial significativo, ya que...
Lee este artículo ahora con una cuenta gratuita.
Tus beneficios:
- Cada mes, puedes leer 5 artículos de la sección premium de forma gratuita.
- Cada mes, 2 números de prueba del periódico Trader de forma gratuita.
- Crea una lista de seguimiento personal con un resumen de las noticias sobre tu acción.



